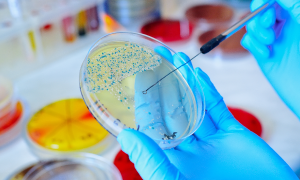
medicina

Semilleros Fármaco-Epidemiología

Semillero Ortopedia

Semillero Otorrinolaringología y organos de los sentidos

Semillero Social y Comunitaria

Fecha última actualización: 12/08/2025
CONTÁCTANOS:
Vicerrectoría de Investigación
Dirección: Carrera 19 No. 8 A-32
Tel: +57 (1) 353 8100 ext. 1601 - 1650
Whatsapp: 57 3245500882
Horario: 7:00 a.m. a 4:00 p.m.
Correo: vicerrectoriainvestigaciones@fucsalud.edu.co
Iniciar sesión

HISTORIA